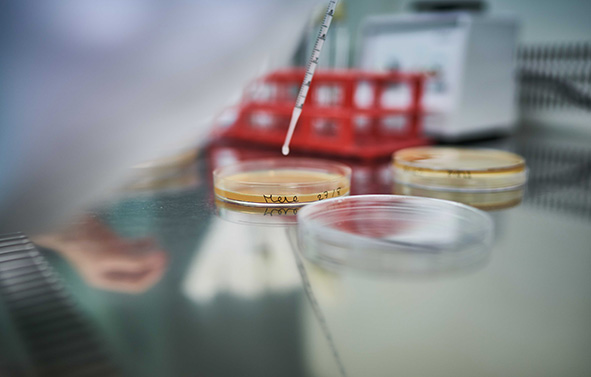
Pipette déposant une goutte de liquide dans une boîte de Petri, sur une paillasse de laboratoire.

Notre mission : Mieux nourrir en respectant l'Homme et la Nature
Située à Crottet, en Auvergne-Rhône-Alpes, Philibert Savours est une entreprise engagée et passionnée, attachée au savoir-faire et à la qualité de ses produits. Depuis nos débuts, nous développons des levains qui reflètent notre exigence, notre créativité et notre respect du vivant.
Pilier 1 - Engagement sociétal

Certification ISO 9001
L’attention que nous portons à la qualité dans toutes nos activités et à la satisfaction de nos clients se reflète dans des processus organisés et maîtrisés, qui garantissent la fiabilité de nos produits et nous permettent de progresser continuellement dans nos performances.
Certification FSSC 22000
Cet engagement traduit notre volonté de garantir la sécurité des denrées alimentaires. Il repose sur une démarche interne rigoureuse qui nous aide à prévenir les risques sanitaires, assurer la traçabilité de nos produits et maintenir un haut niveau d’exigence en matière d’hygiène et de contrôle qualité tout au long de nos activités.
Réintroduction dans les Dombes (Ain) de certaines cultures CRC® et BIO (épeautre, sarrasin, Camp Rémy...).
Mise en place des filières d'approvisionnement régionales avec le contrat quadripartite.
Membre de la Filière CRC® depuis 2003.
Membre de la fondation Terra Isara.
Pilier 2 - Engagement environnemental

Sélection de céréales issues de l'Agriculture Biologique et de la Filière CRC® (Culture Raisonnée Contrôlée) afin de préserver l'environnement, la biodiversité et la juste rémunération des agriculteurs.
Nos biodéchets liquides sont traités par méthanisation ou en épandage direct, tandis que nos biodéchets en poudre sont valorisés en alimentation animale.
Certification ISO 14001
Nous agissons concrètement pour réduire notre impact environnemental en améliorant constamment nos pratiques : optimisation des ressources, recours aux énergies renouvelables, gestion responsable de l’eau, valorisation des déchets et développement de filières agricoles locales et durables.
Pilier 3 - Engagement social

Certification ISO 45001
Nous veillons à la qualité et la sécurité au travail, à travers la mise en place de conditions de travail sûres et saines, la prévention des risques professionnels, l’amélioration de l’ergonomie des postes ainsi que des formations aux métiers.
Nouveaux locaux labellisés BEPOS
Labellisé BEPOS (Bâtiments à Energie POsitive), notre siège social incarne notre engagement en faveur d’un modèle plus durable. Conçu pour optimiser la performance énergétique et réduire notre impact environnemental, ce bâtiment tend vers une quasi-autosuffisance. Il offre également à nos collaborateurs un environnement de travail moderne et qualitatif, favorisant le bien-être au quotidien.
Notre politique d'achat durable et responsable

Dans le cadre de notre politique RSE engagée, nous avons mis en place des filières agricoles et des partenariats avec nos fournisseurs de matières premières afin de vous assurer une certification d’origine.
Cette sélection rigoureuse nous a permis d’élaborer une gamme exclusive de levains actifs et dévitalisés déshydratés bénéficiant de l’appellation «Origine France Garantie», un choix de levains certifiés Bio mais aussi la plus large gamme de levains Filière CRC® réalisés avec des céréales cultivées selon de bonnes pratiques agricoles.
Aussi, nos produits sont certifiés Kasher et Halal, et nos références de fruits sont fabriquées avec des arômes naturels de fruit et des colorants naturels.
Pour aller plus loin, à réception des matières premières, nous réalisons des contrôles qui se poursuivent tout au long du processus de fabrication. Nous appliquons un cycle d’analyses rigoureux, depuis les contrôles à réception jusqu’à l’analyse libératoire du produit fini, avec des critères spécifiques adaptés à chaque référence.
Plus de 25 000 analyses sont réalisées chaque année au sein de notre laboratoire interne. Cette maîtrise complète nous permet non seulement de garantir des produits finis sains et performants, mais aussi de travailler avec notre Institut de Recherche sur des analyses approfondies. Associée à une politique d’achat stricte et à des filières engagées et responsables, cette exigence qualité vous assure des solutions fiables, respectueuses des Hommes et de la Nature.

Nos métiers

Fermentation

Déshydratation & Torréfaction

Conditionnement

Formulation, consulting & initiation

